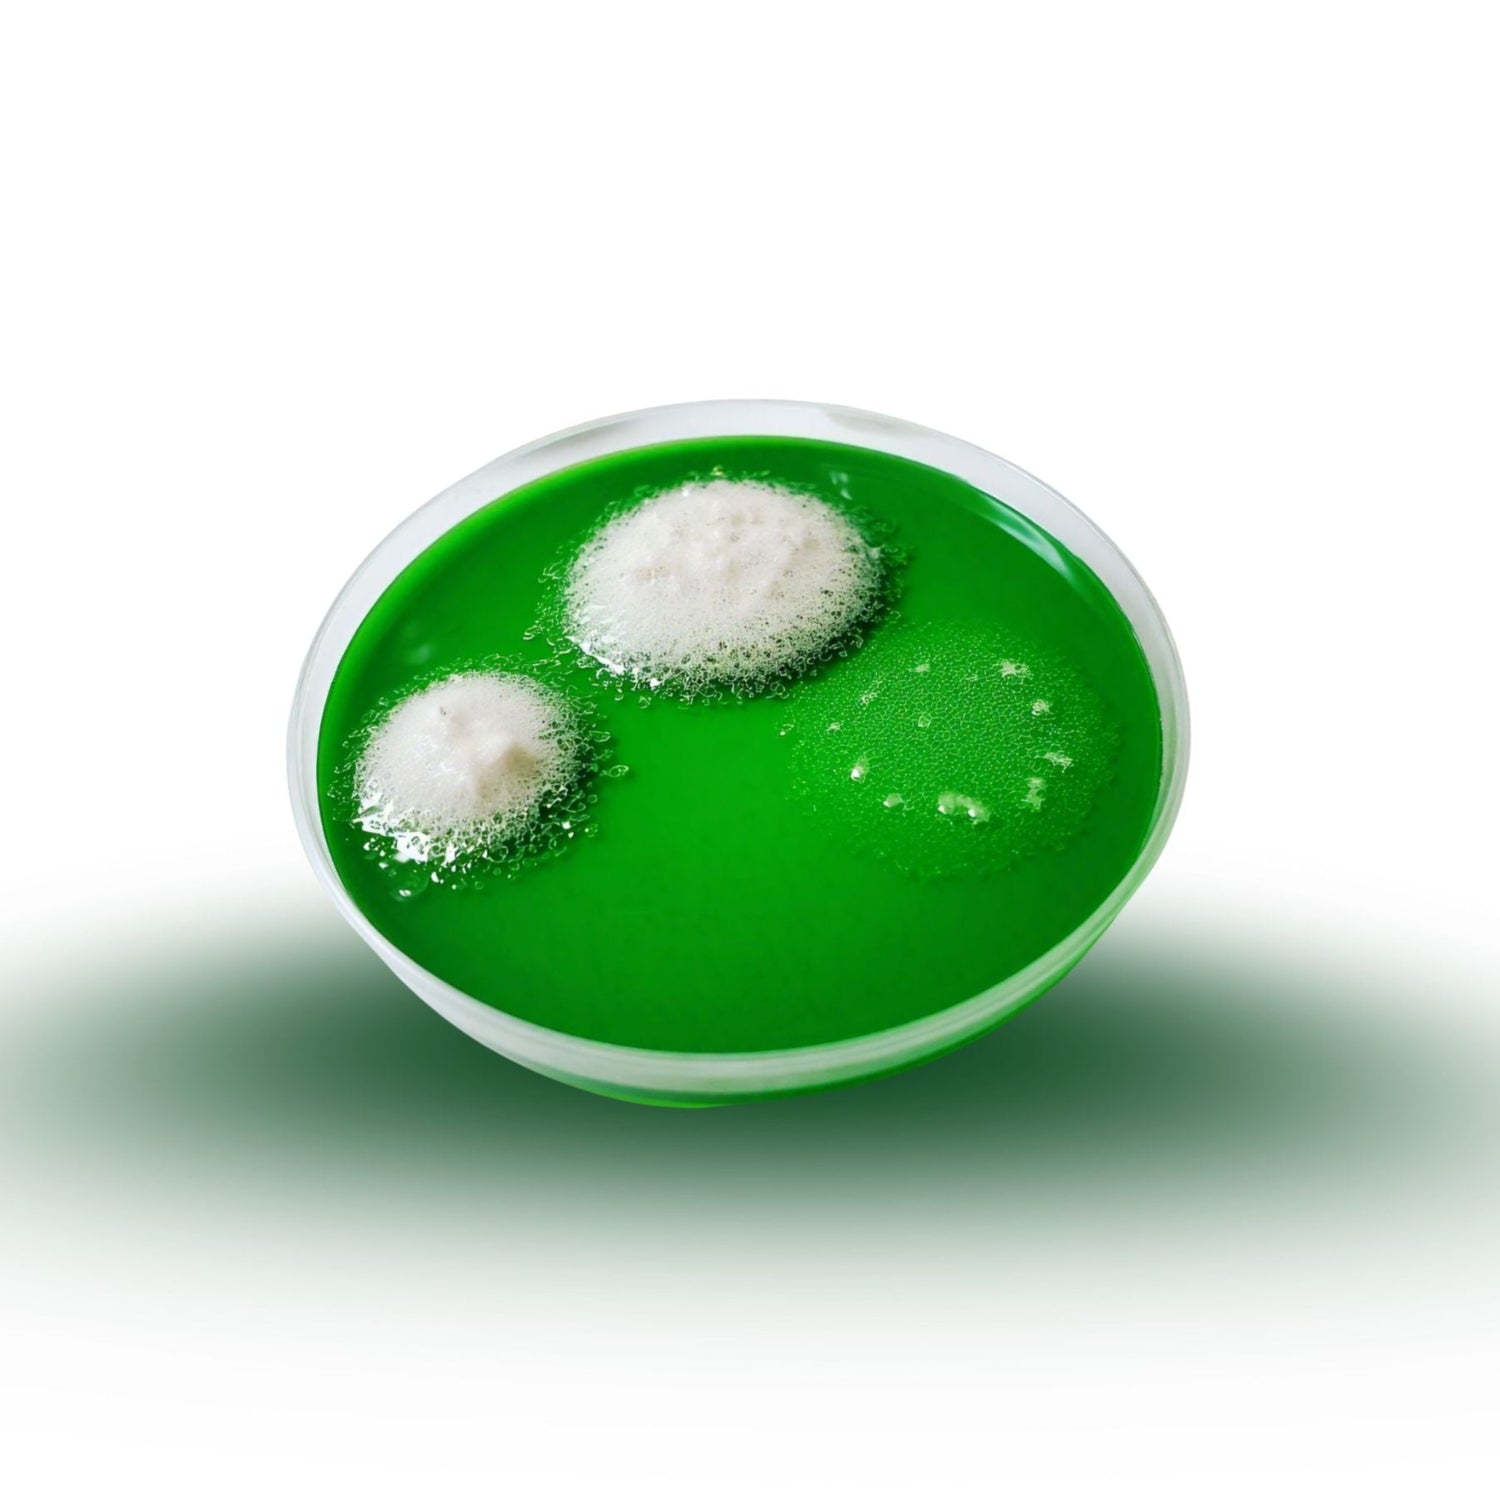

-
What is skin microbiome?
Your skin's health relies on its delicate balance of good and bad bacteria, known as skin microbiome. When in balance, your microbiome protects your skin. But factors like environmental radicals can disrupt this balance, leading to dryness, irritation, inflammation, and sensitivity.
-
What is the Dermabiome Collection from Gleem Beauty?
This scientifically crafted collection is designed to nurture a balanced microbiome, melting away inflammation, dryness, and dullness. Reveal your most luminous, healthy-looking complexion yet - the ultimate symbol of skincare luxury.
-
What skin type is the DermaBiome collection good for?
Suitable for all skin types, even sensitive skin.

Gleem Beauty is revolutionizing skincare with its cutting-edge, scientifically-driven approach to harnessing the power of fermentation ingredients for a balanced skin microbiome. By leveraging the latest advancements in microbiome research, Gleem Beauty's innovative formulas utilize fermented actives to nourish and support the skin's delicate ecosystem, promoting a stronger, more resilient skin barrier and a radiant, healthy glow.
Pictured left: The good and bad bacteria (skin microbiome) that lives on top of your dermal layer
Technology and Science

Harvesting the Power of Nature
Our expertly formulated products, infused with potent, nutrient-rich biotics - including a base of aloe vera, prebiotic Inulin, postbiotic Saccharomyces Ferment, and the powerful Aspergillus Ferment - are designed to nurture a thriving, balanced microbiome. This harmonious blend works synergistically to perfect your skin's delicate pH balance, minimize moisture loss, and reveal a complexion that's truly radiant and resilient.

Aloe Vera
The base of all Gleem Beauty products; Aloe Vera's anti-inflammatory properties make it an effective ingredient for calming and soothing the skin. It reduces redness and irritation, providing long-lasting comfort and hydration to dry and sensitive skin.
Aspergillus Ferment
Works to enhance skin brightness and even out skin tone, giving the complexion a radiant and healthy glow. It also helps to balance the skin's natural pH, reducing the appearance of pores and leaving skin looking smooth and refined.

Saccharomyces Ferment
A powerful ingredient that helps to hydrate and plump the skin, leaving it feeling soft and supple. It also improves skin elasticity, reducing the appearance of fine lines and wrinkles.
Your ultimate microbiome essentials provide long-lasting hydration, nourishment, balance, and protection for radiant, healthy-looking skin. Indulge in the DermaBiome Microbiome Collection, expertly curated to help your skin microbiome flourish. This trio of essentials works in harmony to calm, soothe, and protect your skin, ensuring a glowing complexion that lasts all day and night. Embrace the joy of 24/7 hydration with this simple routine and make this bundle a part of your daily skincare ritual.
